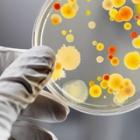

Дети, лекарства, проблемы
> Официальный отдел > Качество медицинской помощи > Дети, лекарства, проблемы
О лекарственных средствах в послед - нее время говорится и пишется очень много. Это и понятно, всех волнует качество препаратов, их доступность. Но в обеспечении лекарствами есть и специфические проблемы. Об одной из них шла речь на форуме “Дети и лекарства”. По инициативе Союза педиатров России, Комитета Госдумы РФ по охране здоровья и спорту, Международного фонда охраны охраны здоровья матери и ребенка, впервые собрались вместе ученые, врачи, фармацевты, представители власти, министерств и ведомств, чтобы обсудить критическую ситуацию, сложившуюся с обеспечением лекарствами детей и подростков.
Приветствуя участников форума, директор Научного центра здоровья детей РАМН, председатель Союза педиатров России, академик А. А. Баранов заметил, что проблемы, связанные с лекарствами для детей, уже вышли за рамки чисто медицинских, стали значительно шире, затронув и социальную сферу. Если раньше педиатры в основном сталкивались с полипрогмазией, самолечением, побочным действием лекарств, то сегодня врачей волнуют совершенно иные вопросы. Им далеко не безразлично, каковы цены на лекарства, их фальсификация, льготы на получение препаратов.
За последние годы значительно возросло количество новых лекарств, но детских форм среди них очень мало. По мнению экспертов, не более 10%. Нет детских дозировок по большинству современных препаратов, поэтому приходится делить таблетки для взрослых на части, а это не всегда можно сделать точно. Отечественные производители вообще перестали разрабатывать детские формы, поскольку дело это очень дорогое и хлопотное, а государственную программу “Детские лекарственные формы” семь лет назад закрыли. Видимо сочли, что можно обойтись и без нее.
А между тем состояние здоровья наших детей не может не тревожить, потому что с каждым годом оно становится все хуже и хуже. На сегодняшний день 90% школьников – больны. За последние 10 лет детей родилось в два раза меньше, чем за предыдущий аналогичный период. Смертность среди подростков за последние три года увеличилась почти на 40%. Эти данные привела на форуме заместитель председателя Комитета Госдумы РФ по охране здоровья и спорту Т. В. Яковлева.
По ее мнению, негативные тенденции обусловлены не только социально-экономическими причинами. Сейчас у врача почти нет возможности лечить детей и проводить профилактику современными лекарствами. Ситуация крайне обострилась после введения 10% ставки НДС на лекарственные средства. Из бюджетов всех уровней увеличились расходы на лекарственное обеспечение детских лечебных учреждений, образовался дефицит лекарств по ряду фармакологических групп.
Серьезная проблема многих десятилетий – специальные лекарственные формы для детей, прежде всего отечественного производства. Особенно в них нуждаются дети первого года жизни. Раньше приготавливали капли, микстуры, порошки в аптеках по прописям врачей. Сейчас из-за нерентабельности число таких аптек резко сократилось, а оставшиеся с большим трудом получают субстанции для изготовления лекарств. Зарубежные фирмы поставляют на российский рынок детские лекарственные формы. Но они слишком дорогие, а отечественная промышленность пока не в состоянии наладить их выпуск.
Заместитель министра здравоохранения РФ, профессор О. В. Шарапова отметила, что цель форума – привлечь внимание широких слоев общественности к самым острым проблемам обеспечения детей и подростков лекарствами и продуктами детского питания. Нынешний форум должен определить пути формирования в России цивилизованного рынка фармацевтической продукции, а также диетического и детского питания, объединить усилия исполнительной, законодательной власти, а также общественных организаций и производителей в решении возникающих проблем.
Состояние здоровья детей О. В. Шарапова тоже охарактеризовала как негативное. В 2001 г. родилось 1,26 млн детей. Это на 48 тыс. больше, чем в 2000 году. Однако, за последние 5 лет заболеваемость новорожденных выросла почти на 27%. Каждый 12 ребенок появляется на свет с низкой массой тела, и число таких детей ежегодно возрастает от 3 до 5%. Три четверти от общего числа недоношенных и маловесных детей нуждаются в проведении очень дорогой, интенсивной терапии, выхаживании и последующей медицинской реабилитации. За последние пять лет общая заболеваемость детей до 15 лет увеличилась почти на 30%. В структуре заболеваний детей всех возрастных групп преобладают болезни органов дыхания, пищеварения, зрения, костно-мышечной системы и соединительной ткани, а также травмы и отравления. Все больше детей становятся инвалидами. На 1 января 2002 г. пенсии или пособия по инвалидности получили 617 тыс.
Решение вопросов, связанных с состоянием здоровья детей, зависит от совершенствования организации медицинской помощи и повышения ее качества. Сейчас проходит Всероссийская диспансеризация детей, которая позволит своевременно начать реабилитацию больных ребятишек, определить объемы финансирования лечения, внедрить новые формы медицинского обслуживания.
Федеральные учреждения здравоохранения располагают сейчас высококвалифицированными кадрами, оснащены современным оборудованием, для диагностики и лечения используют новейшие медицинские технологии. В 2001 г. высокотехнологические дорогостоящие виды медицинской помощи детям оказали в 50 федеральных учреждениях здравоохранения. В 2002 г. Минздрав РФ принял решение увеличить объемы кардиохирургической, ортопедической и нейрохирургической помощи до 70% от всех объемов, финансируемых из бюджета.
О том, что для детей необходимо специально выпускать лекарства, говорил президент Российской фармацевтической ассоциации А. Д Апазов. – Когда мы получили приглашение от Союза педиатров на участие в форуме, то решили проанализировать рынок лекарств, с точки зрения обеспечения детей. Оказалось, что из более чем 13 тыс. зарегистрированных наименований всего 97 детские формы. Из них отечественных лекарств только 36.
Несмотря на то, что за последние годы рынок лекарственных средств значительно вырос, население покупает около 50% нужны препаратов. Надо полагать, что и дети не обеспечены лекарствами на все 100%. При этом доля государства в финансировании лекарственного обеспечения сократилось с 70% в 1996 г. до 30% – в 2001 г. Поэтому врач, как правило, выбирает ребенку лекарство не по жизненным показаниям, а по его стоимости. Позиция нашей Ассоциации такова – дети в любой стране должны иметь приоритет и получать лекарства в полном объеме.
Обмен опытом важен в любом деле, а в медицине и здравоохранении тем более. Поэтому участники форума, особенно те, кто приехал из регионов, с особым вниманием слушали выступление заместителя председателя Комитета здравоохранения Москвы И. А. Лешкевича о льготном обеспечении лекарствами детей и подростков в столице. С 1999 г. система льготного лекарственного обеспечения населения кардинально изменилась. Сейчас в городе льготами пользуются 1 млн 800 тыс. москвичей, в том числе 223,5 тыс. детей. В столице есть единый городской регистр льготного населения по 51 категории, в том числе среди детей – 45. Каждый больной ребенок находится на учете, и при существующем порядке выдачи лекарств есть возможность в любое время проследить, какие препараты врач выписывает и сколько на самом деле получено, задерживается ли выдача лекарств, сколько на это израсходовано средств. Это позволяет планировать финансовые расходы как в лечебном профилактическом учреждении, так и в целом по округу, по городу. На учете – каждая копейка.
За 2001 г. на льготное обслуживание потратили 2 млн руб., это около 3% всех расходов бюджета на лекарственное обеспечение льготной категории населения. Средняя стоимость детского рецепта составила 226 руб., что почти в 2 раза выше, чем средний рецепт для взрослого. Затраты на одного обратившегося составили 713 руб., на ребенка-инвалида – почти 2 тыс., на ребенка с онкологическими заболеваниями – почти 7 тыс., бронхиальной астмой – 727 руб., с гематологическими заболеваниями – 80,5 тыс. руб.
Недавно появилась идея открыть детские специализированные аптеки. В Москве есть 95 аптек, имеющих профиль педиатрии с полным набором детских препаратов, предметов ухода и т. д. Этот эксперимент планируется провести в 10 округах города.
Проблема, которая напрямую зависит от качества лекарственных средств, – клинические испытания. Основным документом, который регламентирует клинические испытания фармакологических препаратов, является Хельсинская декларация 1964 г., содержащая рекомендации для врачей, участвующих в медико-биологических исследованиях, испытаниях, в том числе, и лекарств, – говорит директор Московского НИИ педиатрии и детской хирургии МЗ РФ, главный педиатр Минздрава А. Д. Царегородцев. Очевидно, что в педиатрии допустимы лишь исследования, направленные на улучшение состояния больных ребятишек. Это новые схемы лечения и лекарственные средства, которые прошли все необходимые этапы исследований, предрегистрационные исследования у взрослых и зарегистрированы государственной фармакопеей.
Среди всех клинических исследований допустимыми считаются, лишь открытое и простое слепое исследование, когда и лечащий врач и специалист, мониторирующий исследование, обладают полной информацией об исследуемом препарате, знают, какое оно оказывает действие на организм ребенка и какие последствия может повлечь применение данного фармакологического средства. С этической точки зрения в педиатрии сложности возникают, как правило, при определенной протоколом необходимости проведения плацебоконтролируемого исследования или наблюдения детей, не получавших или не получающих лечения. Проведение таких видов исследований не согласуется с требованием деклараций и допустимы лишь в исключительных случаях, когда отказ от лечения даже на короткое время не скажется на сроках выздоровления и, тем самым, не нанесет ущерба здоровью ребенка. При клинических исследованиях, взрослый пациент может сознательно довериться врачу, ребенок не может. При фармакологических исследованиях в педиатрии возникает сложная схема юридических и этических взаимоотношений, так как разрешение на проведение эксперимента дает либо родитель, либо опекун, который, не подвергаясь фармакологическому воздействию, должен нести юридическую ответственность за результаты исследований непосредственно перед ребенком. Естественно, при выборе характера исследования, педиатр должен отдавать предпочтение неинвазивным, безболезненным методам. Инвазивность исследования должна быть строго ограничена лишь набором методик, направленных исключительно на пользу больного и необходимых по клиническому показанию.
Основная предпосылка, на которой должна строиться любая программа эксперимента, – это признание ребенка личностью, перед которой несут этическую и правовую ответственность как заказчик, организатор исследования и лечащий врач, так и родители, либо опекуны пациента.
Другой аспект фармакологических испытаний на людях вообще, и в педиатрии, в частности, финансовая заинтересованность проводящих их врачей. Очевидно, что любое исследование оплачивается фармацевтической фирмой, которая заинтересована в продвижении своего препарата. Лечащий врач заинтересован лишь в эффективном лечении, в улучшении состояния больного, а отсюда окончательное принятие решения о возможности проведения эксперимента остается за лечащим врачом. Именно поэтому в педиатрии не может широко применяться двойное, тройное слепое исследование. Этический комитет, который работает в педиатрических учреждениях, должен, естественно, учитывать все особенности фармакологических испытаний педиатрии. И еще. Врач, который проводит исследование через страхование, у нас юридически не защищен. За рубежом эта система работает, поэтому в обычной практике и проведении каких-либо исследований врач юридически защищен от необоснованных претензий родителей и родственников, в нашей стране эта работа находится в зачаточном состоянии.
В любом случае основным положением испытания фармакологических препаратов в педиатрии является польза для маленького пациента, и основополагающий принцип врачебной этики “не навреди” становится здесь наиболее актуальным.
Особая проблема в применении лекарственных средств – врачебные ошибки, с которыми довольно часто сталкиваются сейчас родители. По данным директора НИИ антимикробной терапии, академика Л. С. Страчунского, в 50% случаев назначения детям в амбулаторных условиях антибиотиков неоправданы. Зачастую им назначают малоэффективные, устаревшие препараты, иногда даже взаимоисключающие друг друга. Только на непрофессионализм врачей это списать нельзя. Ведь не они виновны в том, что у них нет объективной информации по фармакотерапии. До основной массы врачей она просто не доходит. Поэтому и пользуются они устаревшими руководствами. По нашим данным, полученным в результате анкетирования, менее 5% врачей в регионах пользуются Федеральным руководством для врачей по использованию лекарственных средств. Основным источником информации, как это ни печально, остается справочник Видаля. Для полноценной работы нужно, наконец, издать Федеральный формуляр для врачей-педиатров.
Новые экономические отношения, развивающиеся сейчас в России, повлекли за собой и ряд негативных процессов. К сожалению, они появились и в здравоохранении. Незащищенный фармацевтический рынок стал очень привлекательным для дельцов, подделывающих различные лекарственные препараты. Прокурор Управления по надзору за исполнением законов и законностью правовых актов Генеральной прокуратуры РФ А. А Швецова подробно рассказала на форуме о работе, которую они проводят в сфере незаконного оборота фальсифицированных лекарств.
В последнее время потребительский рынок страны стал насыщаться лекарствами, изготовленными с нарушением технологических процессов, а также реализуемыми с незаконным использованием товарного знака. Применяя такие препараты, тысячи людей подвергают опасности свое здоровье, здоровье близких и детей, не получая должного лечения, усугубляя болезнь. Вот почему фальсификация лекарственных средств является одной из важных проблем в России. Количество реализуемых поддельных лекарств с 1997 по 2000 гг. возросло в 10 раз и продолжает расти. Так, в 2000–2001 гг. было зарегистрировано более 150 серий фальсифицированных лекарств и около 3 тыс. некачественных лекарственных средств. Среди поддельных и некачественных препаратов более 40 наименований. Объем черного рынка составляет около 20–30 млн долларов, при этом 60% подделок производится в России, остальные импортируется из Индии, Китая, стран Юго-Восточной Азии. Более всего подделывают хорошо известные препараты, чаще фальсифицируются противомикробные средства. На долю препаратов этой группы приходится более 47% всех фальсифицированных лекарственных средств. Есть и проблема изготовления лекарств из низкосортных субстанций. В нашей стране производится только 15% субстанций, остальные 85% импортируются из-за рубежа, из которых 45% – из Китая. В ноябре 2001 г. сотрудниками МВД и соответствующими контролирующими органами здравоохранения проведено оперативно-профилактическое мероприятие по выявлению и пресечению фактов изготовления и сбыта фальсифицированных лекарств, а также реализации препаратов с истекшим сроком годности. Проверено 35 тыс. медицинских и фармакологических предприятий и учреждений, а также коммерческих структур. Установлено 227 незаконно действующих предприятий, выявлено более 300 преступлений, в том числе 98 фактов незаконного оборота наркотических и психотропных веществ. Пресечено свыше 6 тыс. административных правонарушений. К ответственности привлечено 1552 человека. Кроме этого, направлено 212 представлений информации в комитеты по лицензированию Минздрава России, приостановлено действие 31 лицензии, аннулированы три. Из оборота изъяты непригодные к употреблению изделия медицинского назначения на общую сумму около 2 млн руб.
Таким образом, состояние законности в сфере производства и оборота лекарственных средств можно охарактеризовать как неудовлетворительное. Что может изменить существующее положение? В первую очередь необходимо изменить подход к осуществлению государственными органами возложенных на них функций на рынке лекарственных средств. Контролирующие органы работают, как правило, по уже совершившимся фактам и мало используют возможности упреждающего контроля на стадии, когда еще не начата реализация лекарственных средств.
Большинство органов по сертификации контроля качества лекарственных средств не имеют надлежащего технического оснащения, что не позволяет своевременно выявлять фальсифицированные лекарственные препараты. Свободная продажа технологического оборудования дает возможность недобросовестным производителям и теневым структурам организовывать производство фальшивых лекарств. Понятно, что при такой ситуации, технические, а значит, и иные преимущества на стороне нарушителей, а не контролирующих органов. Этот вопрос, естественно, требует немедленного решения.
До сих пор нет информационной базы о фактах оборота на российском фармацевтическом рынке фальсифицированной продукции. Нет и статистики о данном виде нарушения и в правоохранительных органах. Наличие такого единого банка данных дало бы возможность эффективнее бороться с фальсификаторами лекарственных средств. Контролирующие правоохранительные органы могли бы владеть полной информацией о производстве и обороте контрабандных лекарств.
В ряде регионов грубо нарушается установленный порядок лицензирования лекарственных средств, есть факты незаконной выдачи лицензий филиалами юридических лиц.
Контрольные органы не всегда применяют к нарушителям исчерпывающие меры воздействия, что негативно влияет на исполнение закона. Нет взаимодействия между контролирующими и правоохранительными структурами. В результате этого, лица, совершившие противоправные деяния, избегают уголовной ответственности и продолжают преступную деятельность.
К сожалению, работу органов внутренних дел по выявлению и пресечению фактов фальсификации лекарств зачастую нельзя признать удовлетворительной. Одна из причин, способствующих реализации подделок, – усложненные, нерегулируемые рынки и схемы распространения лекарств. Продвижением лекарств на рынок занимаются в России более 2 тыс. структур, которые при поставках в розничную торговлю обязаны подтверждать качество продукции, указывая сведения о сертификации в товарно-сопроводительных документах либо предоставляя сертификаты соответствия. Сейчас система отслеживания соответствия поставок контрактам отсутствует.
В настоящее время Минздрав РФ разрабатывает проект федерального закона о внесении изменений и дополнений в закон о лекарственных средствах, где будет дано понятие фальсифицированного лекарственного средства. В Уголовном кодексе РФ появятся дополнения, касающиеся ответственности за изготовление, приобретение и сбыт поддельных лекарств.
Борьба с фармпиратством! Раньше об этом даже не слышали, а теперь подробно об этом рассказывает оперуполномоченный по особо важным делам Отдела по борьбе с преступлениями в сфере интеллектуальной собственности ГУБЭП Службы криминальной милиции МВД России О. А. Дворянкин.
В процессе рыночных преобразований наша страна столкнулась с лавинообразным увеличением масштабов теневой экономики. Именно поэтому малопритягательный, слабоорганизованный внутренний рынок лекарственных средств не смог эффективно защититься от поддельной и некачественной продукции. Учитывая сложившуюся ситуацию, а также слабый контроль со стороны государственных органов за оборотом лекарств, на этом рынке появились люди, которые любым способом решили разбогатеть. При этом их не интересовало ни здоровье людей, ни этические нормы поведения. В список подделок вошли лекарства, жизненно необходимые, важные для человека: антибиотики, лекарства для лечения желудочно-кишечных, сердечно-сосудистых заболеваний, поражения эндокринной и центральной нервной системы, обезболивающие и антигистаминные препараты. По данным исследований, сейчас фальсификация идет в основном по пути уменьшения действующего вещества в препарате. Реже оно заменяется другим. Появляются даже подделки с таким измененным составом, применение которых может повлечь развитие тяжелых осложнений.
По результатам недавнего опроса, проведенного среди крупнейших российских и зарубежных фармпроизводителей, контролирующих свыше 50% фармацевтического рынка России, каждое 10 лекарственное средство – подделка, и ущерб компании превышает 250 млн долларов в год. По другим данным, он достигает 215% от общего рынка лекарственных средств. В сегменте дорогостоящих препаратов, продающихся по очень низкой цене, этот процент составляет 75–90%.
Выделю несколько проблем. После демонополизации фармацевтического рынка количество его участников только за последнее десятилетие возросло в 8 раз. Причем такое звено, как оптовое, увеличилось более, чем в 14 раз, и на сегодняшний день составляет около 3 тыс. компаний. Из них отечественных – более 600, крупных – 70, иностранных – 240. Они и составляют основной рынок. Как показывает практика, многие аптеки просто запутались в этих оптовых поставщиках.
Производители, которые работают на этом рынке, не имеют достаточного опыта в области производства лекарственных средств, не имеют своей службы контроля, которая была раньше, и как результат, не соблюдают технологические параметры.
Все больше увеличивается реестр лекарственных средств – сегодня их свыше 14 тыс. наименований. Если провести анализ, то можно отметить сотни одинаковых наименований. Это связано с тем, что у нас не решена проблема адекватности лекарств. Врачи просто начинают путаться в данных препаратах.
На фармацевтическом рынке продолжает расти торговля с лотков. Это тонары, палатки и т. д.
В 1999 г. был создан отдел по защите объектов интеллектуальной собственности. С этого времени мы считали, что основные усилия наших сотрудников должны быть направлены на совершенствование нормативно-правовой базы, информационно-методическом обеспечении, а также на выявление причин преступлений на фармацевтическом рынке.
Сотрудники органов внутренних дел используют профессиональное мастерство для того, чтобы доказать противоправные действия, влияют на правонарушителей в отсутствие законодательства о поддельных лекарствах. Сейчас вносятся изменения в Закон о лекарственных средствах, Уголовный кодекс, Уголовно-процессуальный кодекс, Кодекс об административных правонарушениях. В ноябре прошлого года в МВД России, был принят проект федерального закона о внесении изменений в ст. 180 – “Незаконное использование товарного знака”.
Учитывая, что с 2005 г. все предприятия, выпускающие лекарственные средства в России, должны перейти на стандарт GMP, мы считаем, что изменить сложившуюся ситуацию в сфере оборота лекарственных средств можно.
Завершился форум принятием резолюции. В ней его участники обратились к Президенту и Правительству страны, выразив надежду, что обсуждение проблем лекарственного обеспечения детей и подростков не останется только на бумаге. Быстро их не решить, но очень важно, чтобы и наше общество о них знало.
Подготовила М. Баринова
16.12.2012Посмотрите также:
 Тест полоски для проверки уровня глюкозы в крови Сахарный дебет весьма каверзное заболевание. Основная проблема заключается том, что из-за... |
 Повышенное ВЧД у ребенка: причины Любой, даже «начинающей», маме понятно, что с малышом все в порядке, когда он... |
 Развитие мелкой моторики у малыша Любой маме прекрасно известно, что развивать мелкую моторику рук у детей очень важно. Тем... |
 Хороший психотерапевт – помощь всегда Порой возникают внутренние проблемы, с которыми Вы не всегда можете справиться. Многие... |
Простудные заболевания у детей Различные простудные заболевания так и липнут к детям, когда ребенок начинает кашлять и... |





